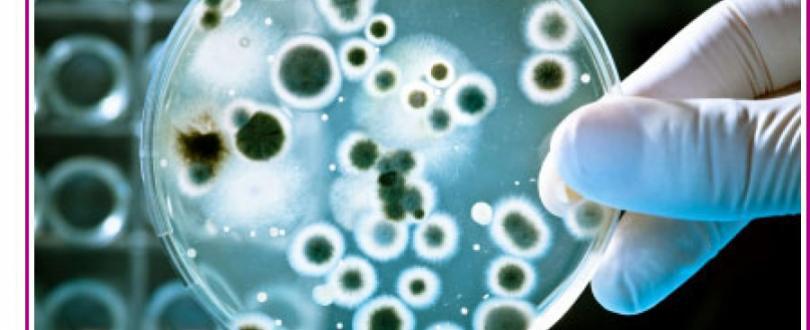

Η νόσος των Λεγεωνάριων μας έλειπε!
Μη εκπλήσσεστε. Μέσα σε όλα τα άλλα κινδυνεύουμε και από τέτοιες εξωτικές ασθένειες εν μέσω κρίσης και οικονομικής δυσχέρειας
Πρόκειται για μια νόσο που ευδοκιμεί στα δίκτυα διανομής νερού των διαφόρων κτιρίων και ειδικότερα στο δίκτυο διακίνησης ζεστού νερού. Η Ελλάδα ως μεσογειακή χώρα διαθέτει θεωρητικά όλες τις προϋποθέσεις για την εμφάνιση λοιμώξεων από legionella, δηλαδή θερμό κλίμα με υψηλές θερμοκρασίες μεγάλης διάρκειας και έντονη λειτουργία των κλιματιστικών. Κρίσιμες θεωρούνται οι μη τουριστικές περίοδοι, κατά τη διάρκεια των οποίων σε ξενοδοχειακές μονάδες που υπολειτουργούν το νερό του δικτύου θεωρείται «στάσιμο», γεγονός που ευνοεί την ανάπτυξη της legionella.

Δεδομένης της κρίσης, είναι απολύτως δεδομένο ότι η συντήρηση έχει περάσει σε δεύτερη μοίρα, οπότε πολλά κλιματιστικά λειτουργούν σε κακή κατάσταση, ενώ συντριβάνια και πισίνες αργούν να καθαριστούν. Η Περιφέρεια Κεντρικής Μακεδονίας εξέδωσε μέτρα προφύλαξης και εφιστά την προσοχή γιατί αυτή η “εξωτική νόσος” δεν αποκλείεται να χτυπήσει την πόρτα μας…
Από τη Διεύθυνση Δημόσιας Υγείας και Κοινωνικής Μέριμνας της Περιφέρειας Κεντρικής Μακεδονίας ανακοινώνονται εν όψει του καλοκαιριού μέτρα προφύλαξης για τη νόσο των Λεγεωναρίων.
Λεγεωνέλλωση είναι η οξεία μικροβιακή λοίμωξη, του ανώτερου αναπνευστικού συστήματος, που προκαλείται από τα βακτηρίδια του γένους legionellae. Ήταν τον Ιούλιο του 1976, κατά την διάρκεια συνεδρίου των Αμερικανών Λεγεωναρίων σε ξενοδοχείο στις ΗΠΑ, όταν εκδηλώθηκε επιδημία άγνωστης μέχρι τότε νόσου. Η νόσος προσέβαλε 200 σύνεδρους, από τους οποίους απεβίωσαν οι 30. Για τον λόγο αυτό, η νεοεμφανισθείσα νόσος, έλαβε το όνομα ‘’ νόσος των λεγεωναρίων’’. Υπάρχουν 50 είδη λεγεωνέλλας, όμως αυτό που προσβάλλει πιο συχνά τον άνθρωπο είναι η legionella pneumophila. Η legionella αναπτύσσεται κυρίως στα επιφανειακά νερά, είναι όμως δυνατόν να ανιχνευθεί και στο καθαρό νερό, όπως και να επιζήσει και στο απεσταγμένο νερό.
Η legionella pneumonophila μεταδίδεται με την αναπνευστική οδό, με την εισπνοή του βακτηριδίου, όταν το νερό που είναι μολυσμένο διασκορπίζεται στον αέρα υπό μορφή σταγονιδίων ( κλιματισμοί, ντουζ, τζακούζι ή spa, σιντριβάνια νερού κ.ά).
Η ασθένεια αυτή δεν μεταδίδεται από άνθρωπο σε άνθρωπο.
Ιδανικές συνθήκες πολλαπλασιασμού του μικροβίου μπορούν να παρουσιαστούν στα δίκτυα διανομής νερού των διαφόρων κτιρίων και ειδικότερα στο δίκτυο διακίνησης ζεστού νερού.
Τα συμπτώματα εκδηλώνονται δύο με δέκα μέρες μετά την μόλυνση. Αρχικά εμφανίζεται πυρετός, βήχας κεφαλαλγία, λήθαργος και διανοητική σύγχυση.
Η λεγεωνέλλωση εμφανίζεται ως άτυπη πνευμονία, με σύγχρονη προσβολή και άλλων οργάνων. Η πνευμονία επεκτείνεται συνήθως και στους δύο πνεύμονες. Συχνή είναι η υπεζωκοτική αντίδραση με πλευριτικό υγρό.
Είναι δυνατή η εμφάνιση εξωπνευμονικών εκδηλώσεων, όπως ενδοκαρδίτιδα, περικαρδίτιδα, διαταραχές ηπατικής και νεφρικής λειτουργίας, μικροβιαιμία κτλ. Κυριότερη επιπλοκή είναι η οξεία νεφρική ανεπάρκεια. Παράγοντες που προδιαθέτουν την νόσο
- Το φύλο ( είναι πιο συχνό στους άντρες από ότι στις γυναίκες)
- Η ηλικία ( συνήθως άνω των 50 ετών)
- Το κάπνισμα
- Ο αλκοολισμός
- Η θεραπεία με ανοσοκατασταλτικά ( πχ οι μεταμοσχευμένοι , AIDS)
- Σε χρόνιες πνευμονοπάθειες
Προληπτικά μέτρα για ατομική προστασία:
- Τακτικός καθαρισμός και συντήρηση στους λέβητες και τα κλιματιστικά
- Συχνός καθαρισμός και χλωρίωση στις κολυμβητικές δεξαμενές (πισίνες)
- Ενημέρωση για τη νόσο κυρίως τον τρόπο μετάδοσης συμπτώματα κ.ά
- Έγκαιρη διάγνωση και κατάλληλη θεραπεία
Προληπτικά μέτρα για την Δημόσια Υγεία
- εντοπισμός της μολυσμένης πηγής
- δειγματοληψία νερού σε συστήματα ύδρευσης και κλιματισμού
- λήψη κατάλληλων μέτρων στη μολυσμένη πηγή
- παρακολούθηση της αποτελεσματικότητας των μέτρων πρόληψης
- και ιδιαίτερη προσοχή κατά την κατασκευή του δικτύου, ώστε οι αγωγοί ψυχρού να μην είναι κοντά με τους αγωγούς του θερμού νερού.
Ιδιαίτερη προσοχή απαιτείται κατά την κατασκευή του δικτύου στα κτίρια, ώστε οι αγωγοί ψυχρού νερού να μην βρίσκονται κοντά στους αγωγούς του θερμού νερού.
Για περισσότερες πληροφορίες σχετικά με τη legionella οι ενδιαφερόμενοι μπορούν να ανατρέχουν στον θεματικό ιστοτόπο του Δικτύου Πρόληψης και Προαγωγής Υγείας της Περιφέρειας Κεντρικής Μακεδονίας, στην ηλεκτρονική διεύθυνση